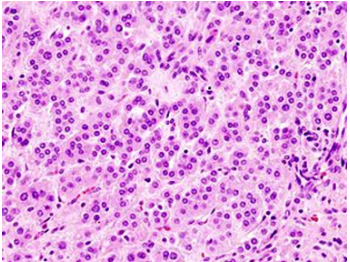

What are some causes or examples of Adrenal hyperactivity?
Primary hyperaldosteronism
Secondary hyperaldosteronism
Bilateral adrenal hyperplasia
Phaeochromocytoma
Neuroblastoma
What is meant by primary hyperaldosteronism?
This is a condition in which there is autonomous production of aldosterone, independant of its regulators (Angiotensin II and potassium)
What are some of the cardiovascular actions of aldosterone?
- Increased sympathetic outflow
- Increased cardiac collagen levels
- Cytokine and ROS synthesis
- Sodium retention
- Increased blood pressure
- Vasoconstriction
What is the most common cause of secondary hypertension?
Primary hyperaldosteronism
What are the main causes of primary hyperaldosteronism?
Adrenal adenoma (Conn’s syndrome)
Bilateral adrenal hyperplasia
Genetic
Unilateral hyperplasia
What are some clinical features of primary hyperaldosteronism?
- Significant hypertension
- Hypokalaemia
- Alkalosis
How is an aldosterone excess confirmed?
- Measure plasma aldosterone and renin and express as a ratio (ARR)
- If ratio raised, then investigate further with saline suppression test
- Failure of plasma aldosterone to suppress by >50% with 2L of normal saline confirms primary aldosteronism
How is the sub-type of primary aldosteronism confirmed?
- Adrenal CT to demonstrate adenoma (Conn’s disease)
- Sometimes adrenal vein sampling to confirm adenoma is a true source of aldosterone excess

What is the main surgical management option for primary hyperaldosteronism?
Unilateral laparoscopic adrenalectomy
What is the medical management of primary hyperaldosteronism?
Spironolactone or eplerenone
What is an adrenal adenoma (Conn’s syndrome)?
Benign neoplasm emerging from the cells of the adrenal cortex
Describe the genetics of adrenal adenoma formation
- KCNJ5 channel is a rectifying selective channel which maintains membrane hyperpolarisation
- Mutations lead to loss of ion selectivity; Na+ entry and depolarisation and therefore increased aldosterone production
Describe the histology of adrenal adenoma
- Composed of cells resembling adrenocortical cells
- Well-differentiated, small nuclei
How will adrenal adenoma present?
- Often asymptomatic
- Excess hormone secretion (E.g. Conn’s syndrome, Cushing’s)
How is adrenal adenoma investigated?
- Imaging (CT, MRI)
- Hormonal testing
How would a small adrenal lesion without biochemical abnormality be managed?
It can be safely left in situ
When would surgical excision of an adrenal adenoma be required?
Functioning lesion
Large lesion >3-5cm as this could be malignant
What is secondary hyperaldosteronism?
Increased adrenal production of aldosterone in response to nonpituitary, extra-adrenal stimuli such as renal hypoperfusion
What causes secondary hyperaldosteronism?
Reduced renal blood flow causes production of excess renin (Physiological response to low BP), causing production of angiotensin II and then aldosterone
What are some causes of reduced renal blood flow?
- Obstructive renal artery disease (eg, atheroma, stenosis)
- Renal vasoconstriction (as occurs in accelerated hypertension)
- Oedematous disorders (e.g. heart failure, cirrhosis with ascites)
What are some causes of renal artery stenosis?
Atherone
Fibromuscular dysplasia (In young females)
How will secondary hyperaldosteronism usually present?
Hypertension
What investigations are required in secondary hyperaldosteronism?
- Renin/aldosterone ratio - high aldosterone and high renin indicates secondary hyperaldosteronism
- Doppler ultrasound, CT angiogram or magnetic resonance angiography (MRA) to look for for renal artery stenosis or obstruction
How is secondary hyperaldosteronism managed?
- Aldosterone antagonists e.g. spironolactone
- Treat underlying cause e.g. percutaneous renal artery angioplasty via the femoral artery to treat in renal artery stenosis


